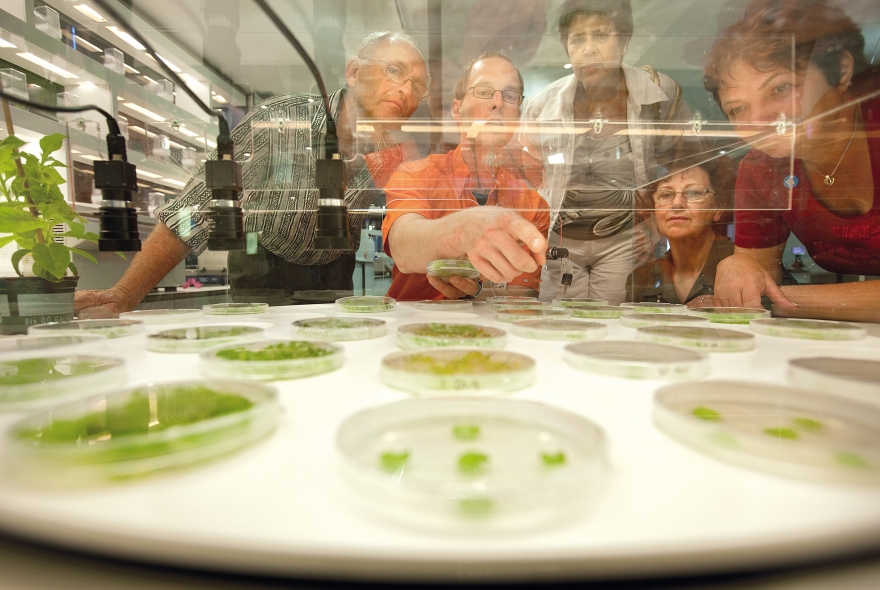
Биолаборатория в Ars Electronica Center

В австрийском Ars Electronica Center уже в 90-х годах пользователи примеряли шлем виртуальной реальности, а сейчас каждый может провести эксперимент по клонированию растений. Арт-директор Музея будущего Герфрид Стокер прибыл в Петербург на сессию Lakhta View, чтобы рассказать, к чему нас приведет цифровая революция.
Как вы попали в проект Ars Electronica?
Я был молодым студентом, когда впервые приехал на фестиваль Ars Electronica — и это изменило мою жизнь. Я впервые увидел тысячи художников, их удивительные работы, сильный потенциал медиаискусства. И я понял, что это не просто мои сумасшедшие придумки, а новое искусство, с которым люди смогут взаимодействовать. Позже я участвовал в фестивале как художник и даже выиграл приз. А в 1995 году начал строиться центр Ars Electronica — и для того, чтобы организовать его работу, как раз набирали молодых талантливых людей. Так я стал частью проекта.
Как было принято решение открыть центр Ars Electronica? И как собиралась первая экспозиция?
Центр стал дополнением к фестивалю Ars Electronica. Но это не просто сбор фестивальных работ или достижений прогресса. В Ars Electronica искусство используется для того, чтобы помочь людям понять технологии и научиться с ними взаимодействовать. Уже в 1996 году у нас в центре были шлемы с мониторами, которые погружали пользователей в виртуальный мир. А сейчас в Ars Electronica Centre все желающие могут клонировать растения, знакомиться с искусственным интеллектом или управлять роботом, надев шлем с электродами.
Нередко современная культура демонизирует технологий: от «Терминатора» до «Черного зеркала». Как вы относитесь к подобным опасениям?
Не нужно забывать, что это мы, люди, создаем технологии. Ни одна микросхема не создавалась без человеческого участия — это же не инопланетяне сбрасывают на нас все эти приборы и фишки. Технологии — часть нашей культуры. Опасаться их — значит бояться самих себя. Если мы просто глупые пользователи — мы испытываем страх, ведь мы не понимаем механизм. Пока человек пассивен во взаимодействии с технологией, он может стать её жертвой. Но когда человек разрабатывает ее, он получает контроль и власть.
Синтоисты уверены, что есть душа у камушка, у ноутбука и других предметов. Но попробуйте поговорить об этом с ученым — и он подумает, что вы сошли с ума. Сегодня мы знаем, почему солнце встает на востоке и отчего бывают приливы. А раньше люди, пытаясь это познать, придумывали богов и духов. Если человечество не сможет понять технологии, то как бы нам снова не скатиться в темные времена. Поэтому нужно добиться знания.
Каким будет этот новый мир?
Впереди большой потенциал для развития технологий машинного обучения и искусственного интеллекта. В ближайшие десять лет мы увидим интересный феномен — больше технологий будет внедряться в систему здравоохранения, потому что в дома престарелых отправится поколение Билла Гейтса и Стива Джобса, а это люди, умеющие пользоваться современными технологиями. Еще, думаю, вскоре может произойти что-то вроде революции против безграничного дата-капитализма, основанного на монетизации данных, ценности информации. Растет новое поколение, для которого все эти технологии — полнейшая обыденность. Моему сыну 16, и для него интернет — то же самое, что и водопровод, он просто есть, и всегда был. Моему поколению было все равно, какую цену платить за подключение, но когда ты подключен постоянно — начинаешь думать о цене.
Какое впечатление на вас произвёл Петербург?
Первое ощущение — история, история и еще раз история. На каждом шагу
восхитительные здания и объекты. Историческое наследие крайне важно сохранять — и меня впечатлило, как за ним ухаживают. Но в тех местах, которые я успел посетить, возникают мысли о том, что забота о прошлом может стать тяжелым бременем и помешать развитию.
Но город тем не менее продолжает развиваться. Видели ли вы небоскреб Лахта Центра?

Комментарии (0)